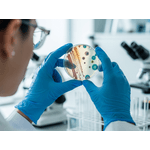

Compreendendo a Microbiologia
Cód:
DN|2189|1966|2966|2138|1770
De: R$ 0,00Por: R$ 14,90ou X de
Preço a vista: R$ 14,90
Descrição do Produto
🔬 COMPREENDENDO A MICROBIOLOGIA
Domine os processos químicos e biólogicos laboratoriais aplicados ao setor industrial.
O curso capacita o participante a entender as principais concepções sobre os processos químicos e microbiológicos, focando nas entradas e saídas de processos industriais, técnicas de laboratório e segurança microbiológica.
📺 Degustação: Introdução ao Conteúdo
🔑 Acesso ao Curso
Comprando aqui no Futuro.Digital:
- ➡Após o pagamento, você receberá as instruções de acesso para a plataforma SENAI Play via e-mail.
⚠
Atenção: Verifique sua caixa de entrada e pasta de spam!
🌟 Por que escolher este curso?
✅
Foco IndustrialEntenda a aplicação real da microbiologia nos processos químicos de fábrica.
✅
Prática LaboratorialAprenda sobre vidrarias, esterilização, meios de cultura e inoculação.
✅
Flexibilidade TotalEstude 100% online na plataforma oficial do SENAI, no seu ritmo.
📝 O que você vai aprender (Ementa)
Módulos 1 ao 3
Grupos de microrganismos, contaminações, fatores de crescimento e esterilização de vidrarias.
Módulos 4 ao 6
Método de Gram, preparo de meios de cultura e estrutura de equipamentos laboratoriais.
Módulos 7 ao 9
Inoculação de fungos e bactérias, técnicas de identificação e contagem de microrganismos.
🎯 Para quem é o curso?
Profissionais da indústria química e de alimentos, estudantes de biologia ou farmácia, e técnicos que buscam especialização em rotinas de laboratório microbiológico.
🎓 Certificação SENAI Play
O Certificado é emitido pela plataforma SENAI Play e estará disponível imediatamente após a conclusão de todos os módulos e avaliações.
Cursos Gerais
| Carga Horária | 20 |
|---|---|
| Compras Realizadas | 2 |
| O que vai aprender? | Conhecer as técnicas de contagem de microrganismos;
Contagem em placa direta. Técnica de diluição para contagem; Cálculo de contagem – UFC/mL; Técnica de números mais provável (NMP); Conceitos básicos de microbiologia; História da microbiologia; Definições dos microrganismos; Classificações quanto suas características; Morfologia e reprodução; Fontes de contaminação: primária, secundária, cruzada, intoxicação alimentar; Riscos de contaminação; Fatores ambientais que interferem no crescimento dos microrganismos (pH, nutrientes, temperatura, oxigênio, umidade, efeito osmótico); Vidrarias e suas funções no cultivo de cultura microbiana; Equipamentos utilizados no laboratório de microbiologia; Preparo de material para esterilização; Remoção, inibição ou morte dos microrganismos por agentes físicos e químicos; Operação da autoclave; Agentes físicos e químicos utilizados no controle dos microrganismos; Métodos de assepsia e antissepsia; Métodos de esterilização e descontaminação; Lavagem de material descontaminado; Método de Gram; Diferença de parede celular de bactérias gram positiva e gram negativa; Preparo do esfregaço e método de coloração; Tipos de corantes empregados no método de Gram; Estrutura e procedimentos de precaução e segurança no laboratório microbiológico; Manuseio e operação dos equipamentos do laboratório microbiológico; Técnicas de semeadura e isolamento de microrganismos (bactérias e fungos); Finalidade do isolamento, semeadura e repique; Diferença entre inóculo, inoculação e incubação; Técnicas de identificação de microrganismos; Tipos de coloração: simples e diferenciadas; Provas bioquímicas utilizadas na identificação de microrganismos; Ações em casos de acidentes com Produtos Químicos derramamentos vazamentos quebras de recipientes ou outros imprevistos envolvendo riscos químicos em potencial; Classes de Risco de Produtos Químicos; Conhecimento e Utilização dos EPIs necessários a cada tipo de risco incluindo-se a Roupa de Proteção Nível B; Identificação dos riscos de acordo com a simbologia (Pictogramas); Incompatibilidade entre os Produtos Químicos; FISPQ - Ficha de Informação de Segurança de Produtos Químicos; Armazenamento de Produtos Químicos; Painel de Segurança - Identificação e Informações contidas; Descarte adequado dos resíduos químicos; Definição de Reação Química; Lei de Lavoisier; Contextualizar a ocorrência das Reações Químicas; Os 04 tipos de Reações Químicas; Introdução aos métodos eletroanalíticos de análises químicas; Técnicas de análise voltamétrica; Técnicas de análise potenciométrica; Técnicas de análise amperométrica; Comparação entre os métodos eletroanalíticos; O que é a Cromatografia e como ela surgiu? |
| Pré-requisito | Não há requisitos. |
| Público-alvo | Estudantes do Ensino Médio, de Nível Técnico e Superior;
Profissionais da indústria; Profissionais autônomos; Interessados em busca de crescimento profissional. |
| Como estudar | EAD |
| Coligada | 3 |
| Processo Seletivo | 120 |
| Nível de Ensino | ES |
| Tipo de Financiamento | 0 |
| Tipo de curso | Micro e Mini Cursos |
| Área Tecnológica | Química |